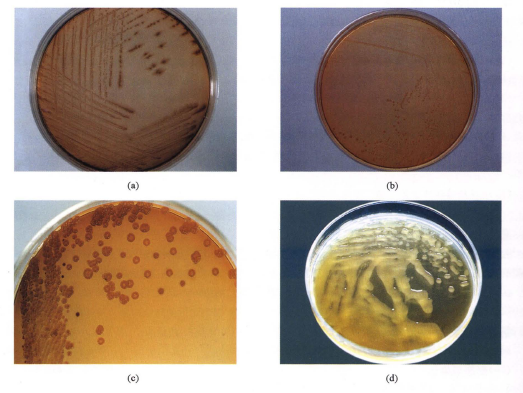

海博微信公众号
海博天猫旗舰店




( 一) 形态与染色
革兰阴性杆菌,菌体细长、且长短不一,有时呈球杆状或线状,成对或短链状排列(图9 - 107). 菌体一端有单鞭毛。
(二)培养特性
在血琼脂平板上35 0C 培养18~24 h ,形成大而扁平、湿润、有金属光泽、蓝绿色、透明溶血环的菌落(图9-108),有生姜味。在麦康凯琼脂平板上,可形成5 种不同的菌落: ①典型型:菌落不规则,边缘呈伞状伸展(图9-109a) ; ②大肠菌样型:菌落圆形凸起,无色透明,似大肠埃希菌菌落(图9 109b) ③粗糙型:菌落呈钮扣状,表面粗糙,或菌落中央隆起边缘扁平(图9 - 109c) ; ④黠液型: 菌落光滑,隆起,呈蒙古液状,嵌入培养基中,不易挑起,似肺炎克雷伯菌菌落,但是无色(图9 - 109d) ; ⑤株儒型:生长缓慢,培养18 h 尚不见菌落, 24 h 后才有细小菌落(图9 -109e) 。
本菌产生两种色素,一种是绿腺素(pyocyanine) ,溶于水和氯仿,为蓝绿色色素(图9-110) ,另一种是荧光素(fluorescence) ,只溶于氯仿,为绿色荧光素(图9 - 111)。
(三〉生化特性
氧化酶试验阳性,分解葡萄糖,不分解乳糖、麦芽糖、甘露醇和煎糖,动力、拘橡酸盐、精氨酸双水解酶和硝酸盐还原试验均阳性,呵|蝶、赖氨酸和鸟氨酸脱援酶试验阴性。
(四〉鉴别要点
1.本菌特征蓝绿色或荧光色菌落、有空姜昧,动力和氧化酶试验阳性,在4 0C 时不生长而在42 0C 时可以生长。
2. 不产色素的铜绿假单胞菌(占4%~10%) 的鉴定氨酸双水解酶试验阳'性,葡萄糖O/ F 试验为氧化型。鞭毛染色呈极端鞭毛(少于3 根) ,动力、氧化酶和精氨酸双水解酶试验阳性,葡萄糖O/ F 试验为氧化型。
3 . 与荧光假羊胞菌和恶臭假羊胞菌的鉴别三者均可产生荧光色素,但铜绿假单胞菌42℃ 时生长,后两者则不能生长。
4 . 与浅黄假羊胞菌、栖稻假羊胞菌的鉴别铜绿假单胞菌氧化酶阳性,可产生蓝绿色色素;而浅黄假单胞菌、栖稻假单胞菌氧化酶阴性。根据七叶昔试验可将浅黄假单胞菌和栖稻假单胞菌加以区别,前者为阳性,后者为阴性。
5 . 与其他假羊胞及类似菌的鉴别见表9 - 31 。
下一篇:溶源性细菌的检查与鉴定
